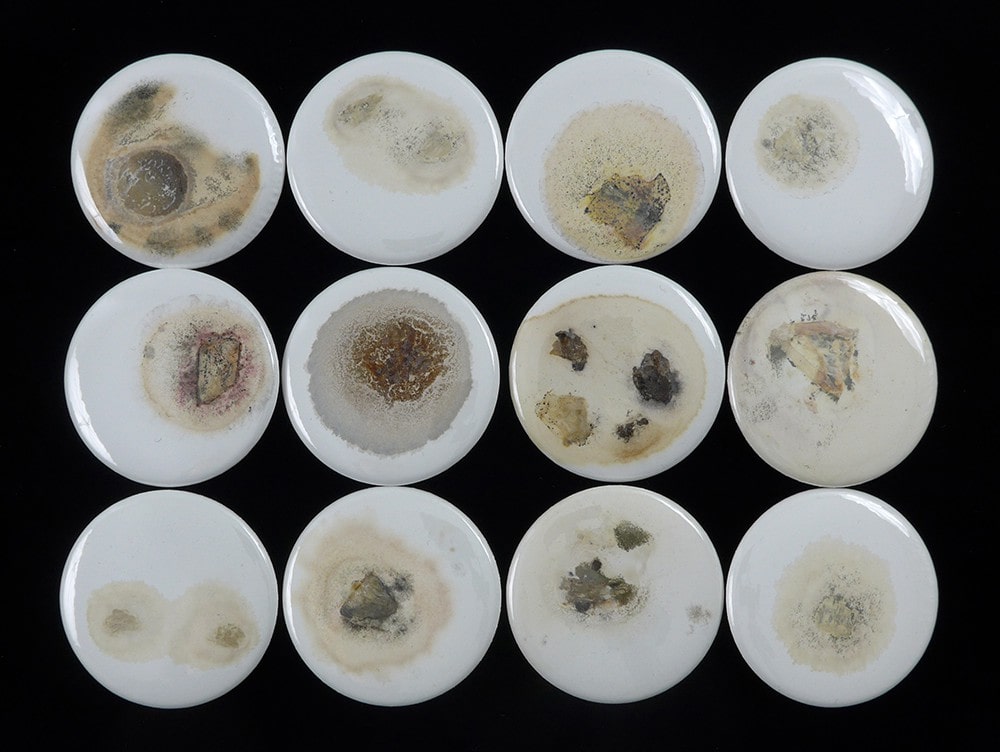

badger’s buttons, Amsterdam
06 50 24 40 61 • info@badgersbuttons.nl • volg ons op Instagram






































06 50 24 40 61 • info@badgersbuttons.nl • volg ons op Instagram